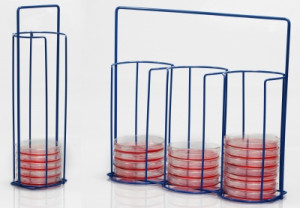

Poxygrid® Petri Dish Carrying Racks
By Bel Art Products
These epoxy coated steel wire racks hold 100mm x 20mm plastic Petri dishes and are easily loaded and emptied from the top. The wide front openings permit easy access but prevent dishes from sliding out. Epoxy coated steel wire is chemical and corrosion resistant and steam autoclavable at 121°C. Not suitable for glass Petri dishes.
